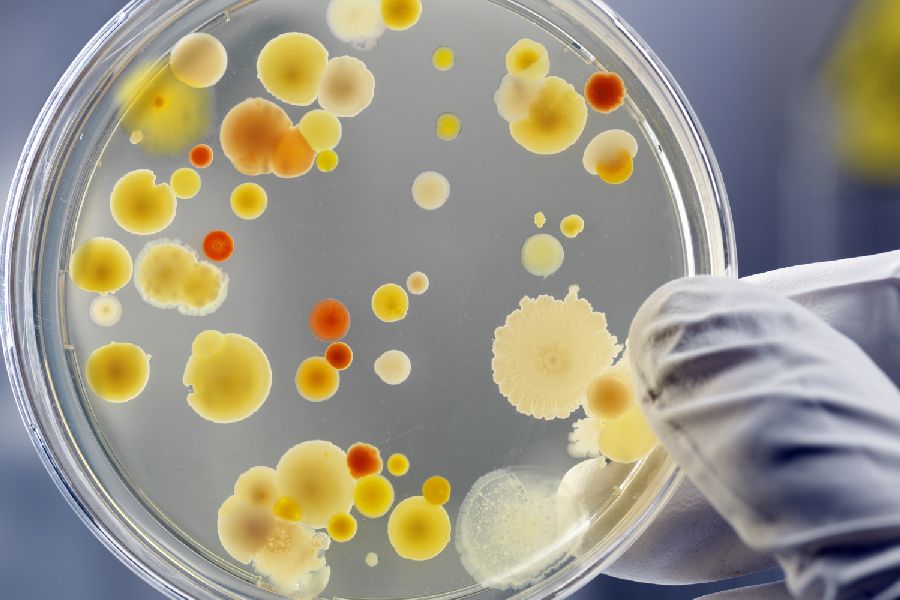
Petrischale mit Bakterien. Per Klick gelangen Sie zur Seite Biologische Arbeitsstoffe

In Schulen ist der Arbeitsschutz ein wichtiger Aspekt, um die Gesundheit und Sicherheit von Schülerinnen und Schülern, Lehrkräften und sonstigen Beschäftigten zu gewährleisten. Im Folgenden sind themenspezifische Hinweise zum Arbeitsschutz in Schulen aufgeführt.